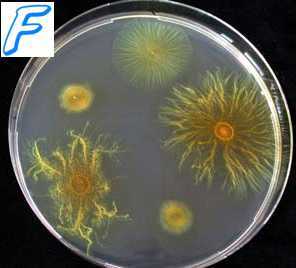
Виды микробиологических исследований. Классификация микробиологических исследований. Микроскопический метод исследования

Микробиологическое исследование. Цель микробиологических исследований. Задачи микробиологических исследований.
Добавил пользователь Алексей Ф. Обновлено: 10.01.2026
Микробиология (от греч. micros – малый, bios – жизнь, logos – учение) – наука о мельчайших невидимых невооруженным взглядом живых объектах – микроорганизмах, закономерностях их развития и тех изменениях, которые они вызывают в среде обитания и в окружающей среде.
Предметом изучения медицинской микробиологии являются болезнетворные (патогенные) и условно-патогенные для человека микроорганизмы, их экология и распространенность, методы их выделения и идентификации, а также вопросы эпидемиологии, специфической терапии и профилактики вызываемых ими заболеваний.
Задачи:
-микробиологическая диагностикa инфекционных заболеваний
-разработка методов спецефической профилактики
-разработка лечения инфекционных заболеваний
2. Санитарная микробиология. Предмет изучения, цели и задачи.
Предмет изучения- санитарно- микробиологическое состояние объектов окружающей среды и пищевых продуктов, разработка санитарно-микробиологических нормативов и методов индикации патогенных микроорганизмов в различных объектах окружающей среды.
-микробиологическое исследование объектов окружающей среды
-оценка микробиологического состояния объектов окружающей среды
-разработка ГОСТов и методических указаний, определяющих соответствие микрофлоры объектов окружающей среды гигиеническим требованиям
-разработка рекомендаций и мероприятий по оздоровлению объектов окружающей среды и контроль за их выполнением
3. Клиническая микробиология: цели и задачи
Клиническая микробиология —это раздел медицинской микробиологии, изучающий УПМ, не имеющие существенного эпидемиологического значения, но в определённых условиях служащих причиной заболеваний; изучает микробные заболевания, возникающие в неинфекционных клиниках.
Цель: клиническая лабораторная диагностика, химиотерапия инфекционных болезней, изучение микробиологической этиологии часто встречающихся в неинфекционных клиниках инфекционных заболеваний.
-изучение роли УПМ в патогенезе инфекционных заболеваний
-разработка методов лабораторной диагностики, этиотропной терапии инфекционных заболеваний в неинфекционных лечебных учреждениях
-мониторинг лекарственной устойчивости возбудителей в ЛПУ
4. Методы исследования в микробиологии. Их диагностическая значимость
• микроскопический - изучение морфологии микробов с использованием специальной микроскопической техники;
• бактериологический (культуральный) - получение чистых культур микробов и изучение их биологических свойств, позволяющие провести идентификацию, т.е. определение, вида микроба;
• серологический - выявление антител к возбудителям в биологических жидкостях организма больного (чаще в сыворотке крови; от лат. serum - сыворотка);
• аллергологический - оценка аллергических феноменов, возникающих в организме человека (на коже, слизистых оболочках или в крови) под действием компонентов или цельных клеток микроба-возбудителя;
• биологический - моделирование инфекционных процессов на лабораторных животных или куриных эмбрионах;
• хемотаксономический - изучение микробов по продуктам их жизнедеятельности непосредственно в организме (без предварительного культивирования на питательных средах). Для этого применяют газовую и газожидкостную хроматографию;
• молекулярно-биологический - изучение состава микробных нуклеиновых кислот с помощью полимеразной цепной реакции, сиквенирования и гибридизации ДНК.
Микробиологическое исследование. Цель микробиологических исследований. Задачи микробиологических исследований.
Основу микробиологической диагностики инфекционных заболеваний составляют микроскопические, микробиологические, биологические, серологические и аллергологические методы.

Микроскопический метод исследования
Микроскопические методы исследований включают приготовление мазков и препаратов для микроскопирования. В большинстве случаев результаты микроскопических исследований носят ориентировочный характер (например, определяют отношение возбудителей к окраске), так как многие микроорганизмы лишены морфологических и тинкториальных особенностей. Тем не менее микроскопией материала можно определить некоторые морфологические признаки возбудителей (наличие ядер, жгутиков, внутриклеточных включений и т.д.), а также установить факт наличия или отсутствия микроорганизмов в присланных образцах.
Микробиологический метод исследования
Микробиологические методы исследований — «золотой стандарт» микробиологической диагностики, так как результаты микробиологических исследований позволяют точно установить факт наличия возбудителя в исследуемом материале. Идентификацию чистых культур (до вида микроорганизма) проводят с учётом морфологических, тинкториальных, культуральных, биохимических, токситенных и антигенных свойств микроорганизма. Большинство исследований включает определение чувствительности к антимикробным препаратам у выделенного возбудителя. Для эпидемиологической оценки роли микроорганизма проводят внутривидовую идентификацию определением фаговаров, биоваров, резистентваров и т.д.
Биологический метод исследования
Биологические методы исследований направлены на определение наличия токсинов возбудителя в исследуемом материале и на обнаружение возбудителя (особенно при незначительном исходном содержании в исследуемом образце). Методы включают заражение лабораторных животных исследуемым материалом с последующим выделением чистой культуры патогена либо установлением факта присутствия микробного токсина и его природы. Моделирование экспериментальных инфекций у чувствительных животных — важный инструмент изучения патогенеза заболевания и характера взаимодействий внутри системы микроорганизм-макроорганизм. Для проведения биологических проб используют только здоровых животных определённых массы тела и возраста. Инфекционный материал вводят внутрь, в дыхательные пути, внутрибрюшинно, внутривенно, внутримышечно, внутрикожно и подкожно, в переднюю камеру глаза, через трепанационное отверстие черепа, субокципитально (в большую цистерну головного мозга). У животных прижизненно забирают кровь, экссудат из брюшины, после гибели — кровь, кусочки различных органов, СМЖ, экссудат из различных полостей.
Информация на сайте подлежит консультации лечащим врачом и не заменяет очной консультации с ним.
См. подробнее в пользовательском соглашении.
Микробиологическая лаборатория. Основные задачи. Правила сбора и транспортировки материала.
Микробиология (от греч. micros – малый, bios – жизнь, logos – учение) – наука, изучающая строение, функции, химическую деятельность, распространение, условия развития, роль и значение в жизни человека весьма малых организмов (микроорганизмов), размеры которых составляют не более 0,1 мм. Преимущественно это грибы, бактерии и вирусы. Они заселили Землю задолго до появления высших растений и животных (около 3–4 млрд лет назад) и в настоящее время являются самой многочисленной и разнообразной группой существ. Несмотря на их малые размеры и массу, микроорганизмы составляют в целом биомассу, больше чем вся биомасса на Земле (растения и животные вместе взятые).
Открытие микроорганизмов относится к концу ХVII в. Открыл их голландский натуралист Антон ванн Левенгук (1632–1723) который сконструировал простейший микроскоп, увеличивающий рассматриваемый объект в 160 раз. В 1698 г. Петр I, находясь в Голландии, посетил Левенгука и привез микроскоп в Россию. Долгое время наука о микробах носила в основном описательный характер – шел так называемый морфологический период развития.
Второй период – физиологический – приходится на ХIХ в., который называют «Золотым веком» и связывают с деятельностью французского ученого Луи Пастера (1822–1895). Пастер установил, что происходящее в виноградном соке спиртовое брожении вызвано жизнедеятельностью микроорганизмов – дрожжей. Большой цикл работ Пастера посвящен изучению причин «болезней» вина и пива, ученый доказал, что их возбудителями являются микроорганизмы, и чтобы предотвратить порчу, предложил прогревать напитки. Этот прием применяют и в настоящее время и называют пастеризацией.
Пастер впервые обнаружил бактерии, не способные развиваться в присутствии кислорода, то есть показал, что жизнь возможна и без кислорода. Он установил, что болезни возникают вследствие заражения особыми микробами и что каждое заболевание вызывается определенным микроорганизмом, он создал предохраняющие прививки и изготовил вакцины против бешенства и сибирской язвы.
Большой вклад в развитие микробиологии внес немецкий ученый Роберт Кох (1843–1910). Им были введены в практику плотные питательные среды для выращивания микроорганизмов, что привело к разработке метода выделения микроорганизмов в так называемые чистые культуры, то есть выращиванию массы клеток каждого вида в отдельности. Р. Кох выявил возбудителя туберкулеза, названного его именем – «палочкой Коха».
Родоначальником русской микробиологии считается И.И. Мечников (1845–1916), он создал фагоцитарную теорию иммунитета, в основе которой лежит способность макроорганизма противостоять инородным телам, в том числе болезнетворным микробам.
Признание огромной роли микроорганизмов в биологически важных круговоротах элементов на Земле, связаны с именами Сергея Николаевича Виноградского и Мартинуса Бейеринка. С.В. Виноградскому принадлежит открытие уникального образа жизни – хемолитрофии (процессы, при которых источником энергии служат окислительно–восстановительные реакции, а донором электронов являются неорганические вещества). Ученые совершили это открытие на примере изучения серных и нитрифицирующих бактерий. Эти же ученые независимо друг от друга показали, что фиксацию молекулярного азота способны производить только микроорганизмы. Виноградским разработан метод накопительных культур.
Конец ХIХ в. ознаменовался еще одним важным открытием в области микробиологии. В 1892 г. Д.И. Ивановский обнаружил вирус табачной мозаики – представителя совершенно новой группы микроскопических микроорганизмов, не имеющих клеточной структуры.
С начала ХХ в. благодаря накопленным знаниям продолжается дальнейшая дифференциация микробиологии, этому способствовало создание электронного микроскопа, который сделал видимым мир вирусов и макромолекулярных соединений. Именно на бактериях О. Эвери, К. Маклеод и М. Мак-Карти доказали роль ДНК в передаче наследственных признаков. Пол Берг в 1972 г. расшифровал геном кишечной палочки, что сделало возможным искусственное конструирование генов и пересадку отдельных генов из одних клеток в другие.
Микробиологическая лаборатория. Основные задачи. Правила сбора и транспортировки материала.
Микробиологическая лаборатория – это компетентная профессиональная организация квалифицированных специалистов, проводящая исследования и диагностику высокого качества в сфере вирусных, грибковых, бактериальных инфекций. Микробиологические исследования осуществляются в рамках научного подхода современными методами. Выбор метода зависит от специфики задач, поставленных перед специалистом.
Цель микробиологических исследований — установить факт наличия или отсутствия возбудителя в организме больного и на объектах окружающей среды.
Задачи микробиологических исследований — идентифицировать микроорганизмы в исследуемом материале, определить их видовую принадлежность, морфологические, биохимические, токсигенные и антигенные свойства, а также установить чувствительность выделенных микроорганизмов к антимикробным препаратам.
Первый этап любого микробиологического исследования составляет правильный выбор материала для исследования. Его определяют свойства возбудителя и патогенез вызываемого им заболевания. При поражениях отдельных органов и систем целесообразно отбирать материал соответствующей локализации. При отсутствии поражений исследуют кровь, а затем отбирают образцы с учётом клинической картины заболевания и доступности материала для исследования. Так, при лихорадке неясного генеза первоначально проводят посев крови; затем, при появлении симптомов более конкретных проявлений, например пневмонии, проводят забор мокроты.
• Образцы материала для микробиологического исследования следует забирать до назначения антимикробной терапии, с соблюдением правил асептики для предупреждения загрязнения материала. Каждый образец следует рассматривать как потенциально опасный. При заборе, транспортировке, хранении и работе с ним необходимо соблюдать правила биологической безопасности. Материал собирают в объёме, достаточном для всего комплекса исследований. Микробиологические исследования следует начинать немедленно после поступления образца в лабораторию.
• Выбор материала для микробиологического исследования должен соответствовать характеру инфекционного процесса. Так, например, при установлении этиологии пневмонии материалом должна быть мокрота, а не слюна, а при раневых инфекциях отделяемое следует забирать из глубины раны, а не с её поверхности.
Лекция №4. Микробиологические методы исследования.
Объект изучения медицинских микробиологических лабораторий — патогенные биологические агенты (ПБА) — патогенные для человека микроорганизмы (вирусы, бактерии, грибы, простейшие), генно-инженерно модифицированные микроорганизмы, яды биологического происхождения (токсины), гельминты, а также материал (включая кровь, биологические жидкости и экскременты организма человека), подозрительный на содержание ПБА.
В зависимости от выполняемых исследований, микробиологические лаборатории подразделяют на диагностические, производственные и научно-исследовательские. В соответствии с типами микроорганизмов, изучаемых в микробиологических лабораториях, выделяют:
С возбудителями инфекционных заболеваний работают только в специализированных микробиологических лабораториях, обеспечивающих безопасность её персонала и невозможность «утечки» патогенных микроорганизмов за пределы лаборатории.
Регламентация условий работы с возбудителями инфекционных заболеваний произведена в соответствии со степенью опасности микроорганизмов для человека. По этому признаку выделено четыре группы возбудителей инфекционных заболеваний.
Группа I возбудителей инфекционных заболеваний: возбудители особо опасных инфекций: чума, натуральная оспа, лихорадки Ласса, Эбола и др.
Группа II возбудителей инфекционных заболеваний: возбудители высококонтагиозных бактериальных грибковых и вирусных инфекций: сибирская язва, холера, лихорадка Скалистых гор, сыпной тиф, бластомикоз, бешенство и др. В эту группу также включён ботулотоксин (но не сам возбудитель ботулизма).
Группа III возбудителей инфекционных заболеваний: возбудители бактериальных грибковых, вирусных и протозойных инфекций, выделенных в отдельные нозологические формы (возбудители коклюша, столбняка, ботулизма, туберкулёза, кандидоза, малярии, лейшманиоза, гриппа, полиомиелита и др.). В эту группу также включены аттенуированные штаммы бактерий групп I, II и III.
Группа IV возбудителей инфекционных заболеваний: возбудители бактериальных, вирусных, грибковых септицемии, менингитов, пневмоний, энтеритов, токсикоинфекций и острых отравлений (возбудители анаэробных газовых инфекций, синегнойной инфекции, аспергиллеза, амебиаза, аденовирусы, герпесвирусы и др.)
В зависимости от уровня безопасности работы с микроорганизмами микробиологические лаборатории подразделяют на четыре группы риска.
Первая группа риска микробиологических лабораторий: лаборатории особого режима (максимально изолированные) с высоким индивидуальным и общественным риском.
Вторая группа риска микробиологических лабораторий: режимные лаборатории (изолированные) с высоким индивидуальным и низким общественным риском.
Третья группа риска микробиологических лабораторий: базовые (основные) лаборатории с умеренным индивидуальным и ограниченным общественным риском.
Четвёртая группа риска микробиологических лабораторий: базовые (основные) лаборатории с низким индивидуальным и общественным риском.
В системе Министерства здравоохранения и Государственного комитета санитарно-эпидемиологического надзора РФ наиболее разветвлена сеть бактериологических лабораторий. В соответствии с выполняемыми задачами выделяют;
• бактериологические лаборатории в составе ЛПУ;
• бактериологические лаборатории в составе комитетов Госсанэпиднадзора;
• учебные бактериологические лаборатории вузов;
• проблемные и отраслевые бактериологические лаборатории научно-исследовательских институтов и предприятий по выпуску бактерийных препаратов;
• специализированные бактериологические лаборатории по контролю за особо опасными инфекциями;
• специализированные бактериологические лаборатории по контролю за отдельными группами бактерий: микобактериями, риккетсиями, лептоспирами и др. Большая часть микробиологических лабораторий работает с ПБА групп III и IV, а изучением возбудителей особо опасных инфекций (группы I и II) занимаются только специализированные лаборатории.
Работу с патогенными биологическими агентами ( ПБА ) групп III и IV выполняют специалисты с высшим и средним специальным образованием. К ней допускают сотрудников, прошедших инструктаж по соблюдению требований безопасности работы с ПБА; последующий инструктаж следует проводить не реже одного раза в год. Все сотрудники, работающие с патогенными биологическими агентами ( ПБА ), должны находиться на диспансерном учёте. Приборы, оборудование и средства измерения должны быть аттестованы, технически исправны и иметь технический паспорт. Их метрологический контроль и техническое освидетельствование следует проводить в установленные сроки.
Из правил работы в грязной зоне базовой микробиологической лаборатории: Перед работой в микробиологической лаборатории следует проверить качество посуды, пипеток, шприцев и другого оборудования. При пипетировании необходимо пользоваться только резиновыми грушами или автоматическими устройствами. Строго запрещено пипетировать материал ртом, переливать его через край сосуда (пробирки, колбы), а также оставлять без надзора рабочее место во время выполнения любых работ с патогенными биологическими агентами ( ПБА ). В грязной зоне микробиологической лаборатории запрещается курить, пить воду, хранить верхнюю одежду, головные уборы, обувь, пищевые продукты. В помещения зоны нельзя приводить детей и домашних животных. Окончание работы в микробиологической лаборатории После окончания работы в микробиологической лаборатории все объекты, содержащие ПБА, должны быть убраны в хранилища (холодильники, термостаты, шкафы) с обязательной дезинфекцией столов. Использованные пипетки полностью (вертикально) погружают в дезинфицирующий раствор, избегая образования пузырьков в каналах. Остатки ПБА, использованную посуду и оборудование собирают в закрывающиеся ёмкости и передают в автоклавную. Категорически запрещено сливать отходы с патогенными биологическими агентами ( ПБА ) в канализацию без предварительного обеззараживания. После окончания работы с патогенными биологическими агентами ( ПБА ) и заражёнными животными, а также после ухода из лаборатории следует тщательно вымыть руки.
Цель микробиологических исследований — установить факт наличия или отсутствия возбудителя в организме больного и на объектах окружающей среды (индефецировать)
Задачи микробиологических исследований — идентифицировать микроорганизмы в исследуемом материале, определить их видовую принадлежность, морфологические, биохимические, токсигенные и антигенные свойства, а также установить чувствительность выделенных микроорганизмов к антимикробным препаратам. Несмотря на то что проведение микробиологических исследований относится к компетенции микробиологов, каждый медицинский работник, имеющий дело с инфекционными заболеваниями, должен знать, как и когда необходимо отбирать материал для исследований, на какие исследования его направлять и как интерпретировать полученные результаты.
Виды микробиологических исследований.
Микроскопические методы исследований включают приготовление мазков и препаратов для микроскопирования. В большинстве случаев результаты микроскопических исследований носят ориентировочный характер (например, определяют отношение возбудителей к окраске), так как многие микроорганизмы лишены морфологических и тинкториальных (особенности окрашивания) особенностей. Тем не менее микроскопией материала можно определить некоторые морфологические признаки возбудителей (наличие ядер, жгутиков, внутриклеточных включений и т.д.), а также установить факт наличия или отсутствия микроорганизмов в присланных образцах.
Серологические методы исследований выявления специфических AT и Аг возбудителя — важный инструмент в диагностике инфекционных заболеваний. Особую ценность они имеют в тех случаях, когда выделить возбудитель не представляется возможным. При этом необходимо выявить повышение титров AT, в связи с чем исследуют парные образцы сыворотки, взятые в интервале 10-20 сут (иногда этот интервал может быть более длительным). AT обычно появляются в крови на 1-2-ю неделю заболевания и циркулируют в организме относительно долго, что позволяет использовать их выявление для ретроспективных эпидемиологических исследований. Определение классов Ig чётко характеризует этапы инфекционного процесса, а также может служить косвенным прогностическим критерием, Особое значение имеют методы выявления микробных Аг. В значимых количествах они появляются уже на самых ранних сроках, что делает их идентификацию важным инструментом экспресс-диагностики инфекционных заболеваний, а количественное их определение в динамике инфекционного процесса служит критерием эффективности проводимой антимикробной терапии.
Аллергологические методы исследования Антигены многих возбудителей обладают сенсибилизирующим действием, что используют для диагностики инфекционных заболеваний, а также при проведении эпидемиологических исследований. Наибольшее распространение нашли кожно-аллергические пробы, включающие внутри-кожное введение Аг (аллергена) с развитием реакции ГЗТ. Кожные пробы нашли применение в диагностике таких заболеваний как сап, мелиоидоз, бруцеллёз. Наиболее известна проба Манту, используемая как для диагностики туберкулёза, так и для оценки невосприимчивости организма к возбудителю.
1.3. Принципы микробиологической диагностики инфекционных заболеваний
Задачи микробиологических исследований — идентифицировать микроорганизмы в исследуемом материале, определить их видовую принадлежность, морфологические, биохимические, токсигенные и антигенные свойства, а также установить чувствительность выделенных микроорганизмов к антимикробным препаратам. Несмотря на то, что проведение микробиологических исследований относится к компетенции микробиологов, каждый врач, имеющий дело с инфекционными заболеваниями, должен знать, как и когда необходимо отбирать материал для исследований, на какие исследования его направлять и как интерпретировать полученные результаты.
Отбор материала.
• Первый этап любого микробиологического исследования составляет правильный выбор материала для исследования. Его определяют свойства возбудителя и патогенез вызываемого им заболевания. При поражениях отдельных органов и систем целесообразно отбирать материал соответствующей локализации. При отсутствии поражений исследуют кровь, а затем отбирают образцы с учётом клинической картины заболевания и доступности материала для исследования. Так, при лихорадке неясного генеза первоначально проводят посев крови; затем, при появлении симптомов более конкретных проявлений, например, пневмонии, проводят забор мокроты.
Образцы следует забирать до назначения антимикробной терапии, с соблюдением правил асептики для предупреждения загрязнения материала. Каждый образец следует рассматривать как потенциально опасный. При заборе, транспортировке, хранении и работе с ним необходимо соблюдать правила биологической безопасности. Материал собирают в объёме достаточном для всего комплекса исследований. Микробиологические исследования следует начинать немедленно после поступления образца в лабораторию.
Выбор материала для исследования должен соответствовать характеру инфекционного процесса. Так, например, для установления этиологии пневмонии материалом должна быть мокрота, а не слюна, а при раневых инфекциях отделяемое следует забирать из глубины раны, а не с её поверхности.
Выбор лабораторных исследований
Основу микробиологической диагностики инфекционных заболеваний составляют микроскопические, микробиологические, биологические, молекулярно-генетический, серологические и кожно-аллергологические методы.
Микроскопический метод основан на микроскопии исследуемого материала, с целью определения формы, взаиморасположения клеток и тинкториальных свойств (тинкториальные свойства – способность воспринимать и удерживать краситель).
Бактериологический метод основан на выделение чистой культуры возбудителя с целью ее идентификации по определенным свойствам (морфологическим, культуральным, биохимическим и др.).
Серологический – основан на выделении в биологических жидкостях (чаще крови) человека специфических антител к соответствующим возбудителям, реже АГ с помощью различных реакций: агглютинации, преципитации, связывания комплимента, иммунной флюоресценции и т.д.
Биологический метод основан на заражение лабораторных животных исследуемым материалом с целью воспроизведения у них инфекционного процесса, постановки реакции нейтрализации и (или) последующего выделения накопленного возбудителя.
Кожно-аллергический метод обнаруживает повышенную чувствительность макроорганизма к определенным возбудителям или продуктам их жизнедеятельности (аллергены), применяются для выявления инфицированности организма (но не заболевания) соответствующим микрорганизмом.
Молекулярно-генетический – позволяет обнаружить возбудитель по нескольким молекулам ДНК, содержащимся в крови или поражённых клетках хозяина. Его целесообразно проводить в случаях, когда:
трудно выделить чистую культуру возбудителя из-за сложности культивирования;
возбудитель характеризуется высокой антигенной изменчивостью;
в исследуемом материале имеется крайне низкая концентрация возбудителя или наблюдается длительная его персистенция в организме человека.
Читайте также:
- Пищевое отравление Listeria monocytogenes и его лечение
- Методы профилактики
- Верапамил и дилтиазем в лечении гипертензии. Эффективность антагонистов кальция
- Методика боковой сфинктеротомии (БС) при анальной трещине
- Интратрахеальное поступление полония. Накопление радиоактивных веществ в критичных органах
